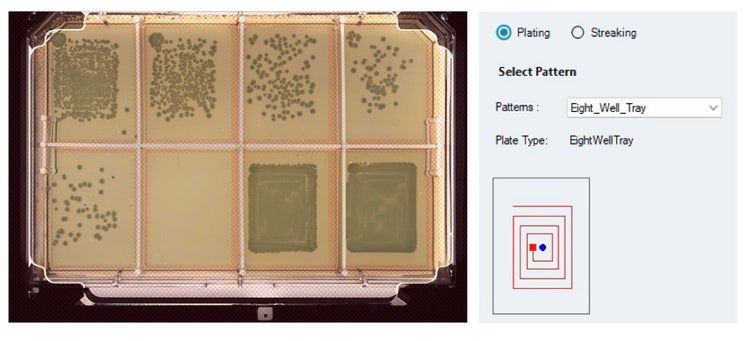
Source culture of E. coli plated on 8-well OmniTray containing LB Agar (with Ampicillin)
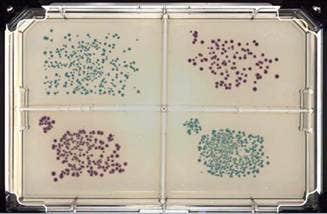
Source culture of E. coli (blue) and Klebsiella(pink) plated on 4-well OmniTray containing ECC CHROMagar
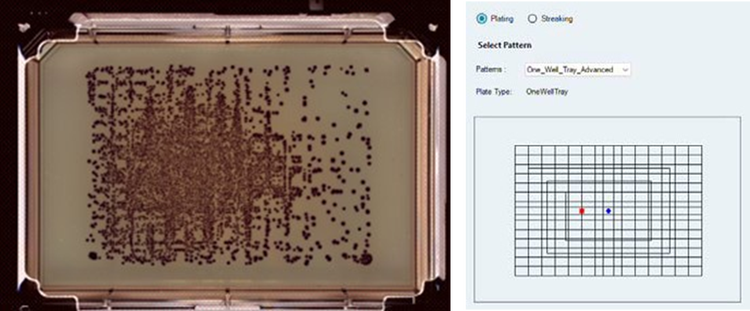
Source culture of Klebsiella aerogenes plated on an undivided OmniTray containing ECC CHROMagar showing isolated pink colonies
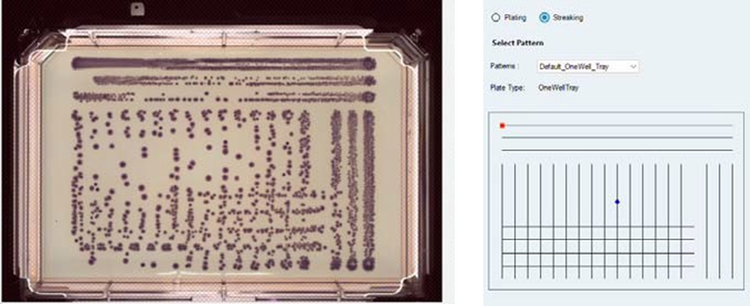
Source culture of Klebsiella aerogenes dip streaked onto an undivided OmniTray containing ECC CHROMagar
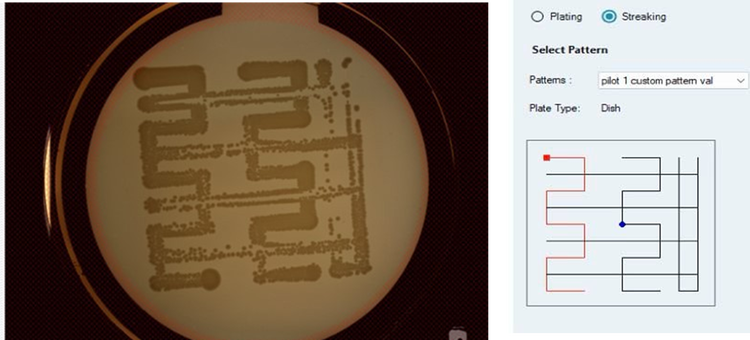
9cm petri dish with LB agar, dip streaked with E. coli using custom user-designed pattern via Streaking Pattern Editor

Application Note
Automating Microbial Plating and Streaking: Advancing Research with the QPix FLEX System
- Ensures consistent colony distribution and highly reproducible streaking and plating patterns, eliminating variability caused by manual techniques.
- Automates labor-intensive plating and streaking using custom disposable tips (Figure 1), significantly reducing hands-on time.
- Integrated UV decontamination, ultrasonic tip washing, and optional HEPA filtration minimize contamination risks.
- Optimizes single-colony isolation, ensuring well- separated colonies for downstream applications such as antibiotic susceptibility testing and genetic analysis.
Sushmita Sudarshan, Prathyushakrishna Macha, Molecular Devices, LLC
Introduction
Microbiology laboratories rely on precision, reproducibility, and efficiency to ensure reliable microbial culture analysis. Traditional manual plating and streaking methods, while effective, are prone to variability, labor-intensive handling, and contamination risks. As research demands increase and high-throughput workflows become essential, the need for automated plating and streaking systems has grown significantly.
Automated technologies standardize microbial distribution, minimizing human error while maintaining sterility throughout the inoculation process. These systems optimize colony isolation, plating consistency, and workflow efficiency, enabling microbiologists to scale their experiments and streamline microbial screening processes. Additionally, automation reduces operator fatigue, enhances data integrity, and supports large-scale applications, making it a critical advancement in modern microbiology research and clinical diagnostics.
The QPix® FLEX™ Microbial Colony Picker enhances microbial research by automating colony plating and streaking, and sample traceability, enhancing data integrity and reproducibility and eliminating labor-intensive processes while maintaining a compact design that fits seamlessly on a benchtop or within a hypoxic chamber. By streamlining essential microbial workflows and optimizing sample selection, the QPix FLEX system boosts research efficiency and reduces manual effort, allowing scientists to focus on discovery rather than routine tasks.
This study validates the precision, reliability, and efficiency of the automated plating and streaking capabilities of the QPix FLEX system. By eliminating the variability associated with manual microbial handling, the system ensures consistent colony distribution, enhances single-colony isolation, and maintains a sterile workflow throughout the plating and streaking process.

Figure 1. Custom disposable plating/streaking tips (300 µL volume) used for liquid aspiration, dispense, and spreading, support plating/ streaking of microbial (culture) samples onto agar filled trays.
Materials
Escherichia coli bacterial strain – JM109-WHITE - JM109 strain transformed with pGemT vector (Promega kit A3600) (AmpR+)
Escherichia coli bacterial strain – JM109-BLUE - JM109 strain transformed with pGemT vector+control insert (Promega kit A3600), Produces blue color when grown on X-Gal/IPTG-containing media. (AmpR+)
Klebsiella aerogenes (ATCC – Fisher scientific)
Undivided Omni Tray – ThermoScientific 264728
Petri Dish 9cm- Greiner 633180
OmniTray 8-Well divider
OmniTray 4-Well divider
LB Agar media, with antibiotics (Ampicillin)
ECC CHROMagar media

Methods
Plating
- To evaluate bacterial growth and optimize automated plating using the QPix FLEX system, we conducted a series of plating experiments involving Escherichia coli and Klebsiella aerogenes species.
- E. coli was plated on LB and LB + ampicillin agar plates, while ECC CHROMagar was used to distinguish Klebsiella aerogenes (purple colonies) from E. coli (blue colonies).
- Serial dilutions of both bacterial strains were prepared and uploaded to the system as source files for each run.
- For 8-well and 4-well divided plates, standard plating patterns were applied, while OmniTray plates utilized advanced plating patterns provided by the QPix FLEX software.
- Various dilutions and bacterial volumes were plated across different regions or plate formats, and colony growth was observed after overnight incubation at 37º C, using the system’s integrated imaging tool in the picking process.
Streaking
- Bacterial samples were streaked onto agar plates on the QPix FLEX using the custom tips to isolate individual colonies, promote growth, and enable observation of colony morphology and purity.
- Source culture volume dispense was not utilized in streaking functionality; the tip is just dipped in a higher concentration of bacteria or an overnight culture to streak.
- Overnight pre-prepared bacterial cultures (grown at 37ºC) were dip-streaked onto LB Agar and ECC CHROMagar plates.
- Various streaking patterns were used, as listed in the results section. Additionally, the Custom Streaking Pattern Editor was employed to design new patterns, which were applied to standard 9 cm LB agar petri dishes.
- The plates were incubated overnight at 37ºC, and the resulting streak patterns/bacterial colonies on the agar plates were imaged the following day using the instrument’s integrated imaging system in the colony picking process.
Optimization
- Optimization of the vertical height for plating and streaking above the agar surface led to consistent and successful runs, resolving early variability and enhancing overall reliability.
- Switching to clean source culture samples for plating effectively eliminated any cross-contamination issues when working with multiple bacterial strains, enabling more accurate and reproducible results.
Additional notes
- Agar height within the destination tray and source culture density significantly influenced both the appearance of the streak patterns and the number of resulting colonies. Optimization of the plating agar height across the three instruments yielded a range between -1.3 and -0.5 mm.
- Plating time depends on the source plate map and waste disposal settings in the protocol. Advanced plating mode led to longer run times due to increased pattern complexity.
Software Setup
- In the Deck Layout area, the deck layout position(s) were selected to define the settings for that position on the instrument deck. This position was defined as either a Source plate, a Destination plate, a TipBox or as None if the position is not being used in the run.
- The figure below (Figure 2) displays a software interface showing deck locations and a source plate map. To define a source plate map in the software, Control and Sample liquids were added by specifying their name, type (sample or control), color, liquid class, and volume. These defined liquids were assigned to specific wells by selecting the desired area on the plate map, right-clicking, and choosing the appropriate sample or control to populate the source wells. Location 3 contains a 96-well source plate with various dilutions of E. coli and Klebsiella aerogenes. These bacterial dilutions were used for plating onto destination agar plates.
- The plating or streaking height above the agar varied slightly between instruments and required optimization prior to conducting the experiments.
- The Destination Plate map, which defines the placement of each source sample onto the destination plate, was configured based on the sample layout of the Source plate (Figure 3).
- The Plate Map(s) both source and Destination were exported and reused where necessary by importing them as needed.

Figure 2. The software interface displaying deck locations alongside a source plate map, where Location 3 houses a 96-well source plate containing various dilutions of E. coli and Klebsiella.
Plating and Streaking was carried out in triplicates and data was analyzed across three different QPix FLEX instruments.
Results
To evaluate the performance and consistency of automated microbial handling using the QPix FLEX system, a series of plating and streaking experiments were conducted in triplicate across three independent instruments. These experiments encompassed both regular and advanced plating techniques, as well as standard and custom streaking protocols, applied to bacterial strains E. coli JM109 expressing β-galactosidase and Klebsiella aerogenes. The results demonstrate the system’s capability to produce reproducible and precise colony distributions, maintain sterility, and support phenotypic differentiation on selective and chromogenic media. The following sections present representative images and observations that highlight the accuracy, reliability, and versatility of the QPix FLEX platform.
Regular Plating
Figure 4 represents a series of dilutions of E. coli JM109 expressing β-galactosidase, plated on LB agar (supplemented with 25 µg/mL ampicillin) using the software’s plating pattern. In the highest concentration region (Bottom right region of Figure 4), a dense bacterial lawn is observed, indicating robust growth. As the dilution factor increases, distinct blue colonies emerge, confirming successful plating of the various dilutions as well as lacZ gene expression. The media control region remains devoid of any bacterial growth, validating the accuracy of the plating process and the effectiveness of environmental sterility. This image was acquired using the QPix FLEX system, configured with a transmission setting of 100 for optimal visualization.

Figure 3. Example Destination Plate Map outlines the placement of specific source samples onto the destination plate, guiding plating or streaking locations for accurate sample transfer.
Figure 4. Source culture of E. coli plated on 8-well OmniTray containing LB Agar (with Ampicillin). Each region of the plate represents a different dilution of the source culture (lowest dilution at the bottom right and highest dilution at the bottom left corner.) The colonies were plated utilizing the plating pattern shown on the right.
Figure 5 presents a 4-well ECC CHROMagar plate, plated using the software’s plating pattern with two distinct concentrations of Klebsiella aerogenes (purple) as well as E. coli (Blue). Clear color differentiation and precise colony distribution were observed, demonstrating the effectiveness of the automated plating process.
Figure 5. Source culture of E. coli (blue) and Klebsiella(pink) plated on 4-well OmniTray containing ECC CHROMagar. The colonies were plated utilizing the plating pattern shown in Figure 4.
Advanced Plating
Figure 6 represents a 1-well Omni tray containing ECC CHROMagar plated with Klebsiella aerogenes (purple colonies) using the software’s advanced Plating Pattern. The plating pattern was clearly visible, demonstrating consistent colony distribution across the plate.
Figure 6. Source culture of Klebsiella aerogenes plated on an undivided OmniTray containing ECC CHROMagar showing isolated pink colonies. The colonies were plated utilizing the plating pattern shown.
Streaking
Regular Streaking
The image (Figure 7) depicts a 1-well OmniTray onto which dip streaking was performed using Klebsiella aerogenes, following a standard streaking pattern. The streaking process involved direct contact between the inoculation tip and the agar surface, without the use of a predetermined culture volume. This facilitates the isolation of single colonies from a source culture of unknown concentration, eliminating the need for pre-made dilutions while ensuring isolated single colony formation.
Figure 7. Source culture of Klebsiella aerogenes dip streaked onto an undivided OmniTray containing ECC CHROMagar. The colonies were streaked utilizing the streaking pattern shown above. The pattern led to generation of isolated single colonies from a dense overnight source bacterial culture.
The image (Figure 8) depicts a 4-well divided OmniTray with LB agar containing 25 µg/ml Ampicillin that was dip- streaked with blue E. coli (β-galactosidase-expressing) overnight culture.

Figure 8. Source culture of E. coli dip streaked an on a 4-well OmniTray containing ECC CHROMagar. The colonies were streaked utilizing the streaking pattern shown above.
The image below (Figure 9) shows a standard petri dish with LB agar that was dip streaked using an E. coli overnight culture, following a custom streaking pattern designed by the user with the Streaking Pattern Editor. This method directly transferred the source bacterial culture onto the agar surface of the destination tray in the custom pattern, facilitating colony distribution and isolation without the need for dilution.
Figure 9. A standard petri dish (9cm) containing LB agar was dip streaked using an overnight culture of E. coli, following a custom streaking pattern designed by the user via the Streaking Pattern Editor.
Conclusion
The tests conducted in triplicate across three instruments demonstrated high consistency, reproducibility, and reliability in microbial plating and streaking automation. Results showed minimal variation between replicates in terms of pattern (See Results section), accuracy and speed (Table 1 and 2), confirming instrument precision and ensuring the validity of automated processes across multiple setups.
The observed uniform colony distribution, sterility maintenance, and accuracy highlight the robustness of the system in handling diverse microbial workflows. The consistency of outcomes across different instruments reinforces confidence, making this automated approach well-suited for microbiological applications.
Table 1. Performance metrics for Plating Process across all three instruments tested.
Table 2. Performance metrics for Streaking Process across all three instruments tested.
Summary
The implementation of automated plating and streaking techniques has proven to be a reliable and efficient approach for microbial strain isolation and colony management. The results of the plating tests demonstrated consistent and well-defined colony distribution, underscoring the precision and reproducibility of the automated system. Notably, the observed variation in colony clustering at different concentrations highlights the importance of optimizing dilution parameters to enhance single-colony isolation and downstream analysis.
The system’s flexibility in accommodating various plating configurations and custom streaking patterns further supports its adaptability to specialized microbiological workflows. While the current setup successfully produced isolated colonies, minor adjustments to the dilution of the source culture could further improve colony separation and identification.
Beyond technical performance, the integration of plating and streaking capabilities into automated colony pickers presents significant advantages for microbiology applications such as microbial strain library generation, antibiotic susceptibility testing, and synthetic biology workflows which benefit from the system’s ability to deliver uniform, reproducible results.
Overall, the findings confirm that automated plating and streaking systems not only streamline microbial workflows but also improve accuracy, reliability, and sample traceability—making them essential tools in both research and industrial microbiology.